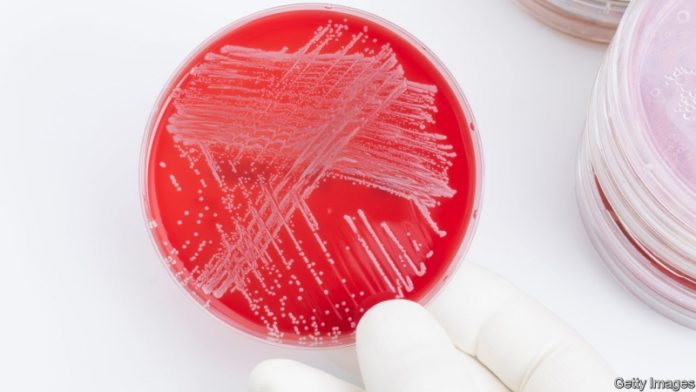

They hope to be able to create new vaccines in just four months
 January 18, 2019
January 18, 2019
Last year the World Health Organisation published a plan to accelerate research into pathogens that could cause public-health emergencies. One priority was the bafflingly named “Disease x”. The xstands for unexpected, and represents concern that the next big epidemic might be caused by something currently unknown.
Preparing for such an eventuality is challenging, but not impossible. That, at least, is the view of the Coalition for Epidemic Preparedness Innovations (cepi), a charity in Oslo, Norway. Over the past few years cepi has spent more than $250m trying to accelerate progress in vaccines for Lassa fever, mers and Nipah virus. Work on Rift Valley fever and Chikungunya should start soon.
Read More HERE